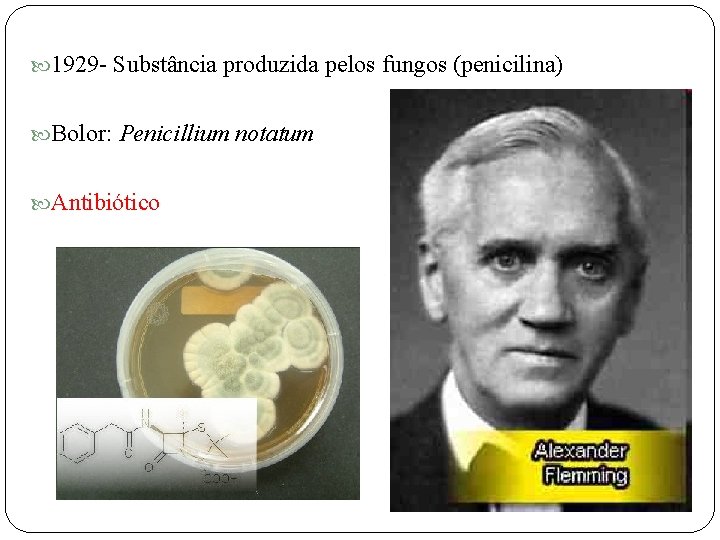
1929 - Substância produzida pelos fungos (penicilina) Bolor: Penicillium notatum Antibiótico

FUNGOS Fungos Reino Fungi 70 mil sp Eucariontes





















- Slides: 21

FUNGOS


Fungos Reino Fungi 70 mil sp Eucariontes aclorofilados Uni ou pluricelulares Ambientes úmidos ricos em MO Heterótrofos - Parasitas e decompositores

Diferenças FUNGOS PLANTAS Não formam tecidos verdadeiros Tecidos especializados Parede celular de quitina Parede celular de celulose Substância de reserva: glicogênio Substância de reserva: amido Nutrição: absorção Nutrição: fotossíntese

Fungos Microscópicos Levedos - Sccharomyces cerevisiae Pão, cachaça, cerveja, vinho Fermentação Reprodução: brotamento Glicose → álcool etílico + gás carbônico


Fungos Pluricelulares Corpo constituído por 2 componentes Reprodução - Esporos no ar Chapéu Lamelas

Micélio – mantém o fungo vivo - Atividade decompositora das hifas Hifas - Células com parede celular de quitina

Lamelas Hifas Micélio

Hifas exteriorizadas forma corpo vegetativo - Bolor, mofo, orelha-de-pau

CICLO REPRODUTOR GERAL Estrutura formadora de esporos (n) Esporos (n) Reprodução Assexuada Germinação Haplóide (n) Dicariótico (n + n) Diplóide (2 n) Estágio dicariótico (n + n) Plasmogamia (fusão do citoplasma) Micélio (n) Reprodução Sexuada Cariogamia (fusão dos núcleos) Estágio diplóide (2 n) Esporos (n) Meiose Estrutura formadora de esporos (n)

Nutrição Absorção da matéria orgânica por ele decomposta Hifas secretam enzimas digestivas enzimas Moléculas absorvidas pelas hifas Pão digerido

Importância dos Fungos Papel ecológico - Decomposição

- Liquens (algas e fungos) - Micorrizas (raízes e fungos) Planta fornece energia e carbono, enquanto os fungos absorvem minerais e água do solo, transferindo-os para a planta

Importância dos Fungos Médica - Micoses
1929 - Substância produzida pelos fungos (penicilina) Bolor: Penicillium notatum Antibiótico


Prevenção contra micoses: -Higiene; -Evitar calor e umidade em áreas de dobras da pele; -Evitar ficar com roupas úmidas; -Usar meias limpas e secas; - Manter as unhas curtas e limpas.

Importância dos Fungos Alimentação - Champignon - Morchella - Truta - Shiitake

Importância dos Fungos Alucinógenos - Cogumelos que crescem sobre esterco – morte

Importância dos Fungos Agrícola - Doenças em plantas - Claviceps sp produz a ergotamina – Esporão do centeio - Ergotamina - LSD